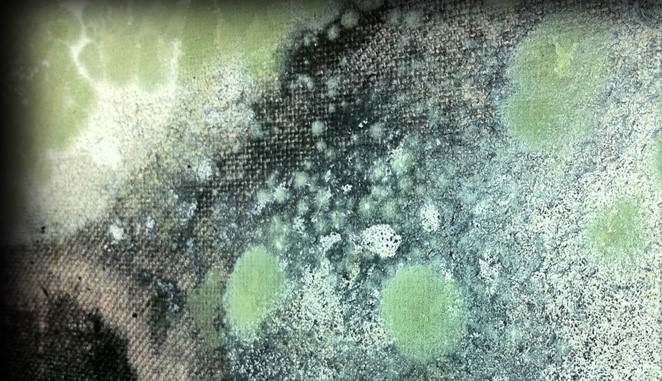

Create an account
Welcome! Register for an account
La password verrà inviata via email.
Recupero della password
Recupera la tua password
La password verrà inviata via email.
-
- container colonna1
- Categorie
- #iorestoacasa
- Agenda
- Archeologia
- Architettura
- Arte antica
- Arte contemporanea
- Arte moderna
- Arti performative
- Attualità
- Bandi e concorsi
- Beni culturali
- Cinema
- Contest
- Danza
- Design
- Diritto
- Eventi
- Fiere e manifestazioni
- Film e serie tv
- Formazione
- Fotografia
- Libri ed editoria
- Mercato
- MIC Ministero della Cultura
- Moda
- Musei
- Musica
- Opening
- Personaggi
- Politica e opinioni
- Street Art
- Teatro
- Viaggi
- Categorie
- container colonna2
- Servizi
- Sezioni
- container colonna1
Ttozoi – (R)evolution
(R)EVOLUTION presenta una selezione di lavori inediti di TTozoi, ottenuti mediante un processo fisico-chimico naturale di proliferazioine di muffe, predisposto e giornalmente interagito dagli artisti.Nelle muffe dei TTozoi una natura informe attacca la tela e compone il lavoro.
Comunicato stampa
Segnala l'evento
(R)EVOLUTION è la mostra personale di Stefano Forgione (Avellino 1969) e Pino Rossi (Napoli 1972) in arte TTozoi a cura di Gaia Pasi.
La ricerca dei TTozoi muove dallo studio delle avanguardie storiche, dalle operazioni fenomenologiche dadaiste (dove la componente del caso gioca un ruolo determinante), dalle comparazioni kandinskyane dove “musica è colore, riverbero è azione, colore è capacità artistica ed espressione della natura, biomorfismo”. Esperienze queste che colpiscono l’immaginario dei TTozoi tanto quanto l’approccio operativo e il risultato informale delle opere, composte di gesto, segno e materia.
(R)EVOLUTION presenta una selezione di lavori inediti di TTozoi, ottenuti mediante un processo fisico-chimico naturale predisposto e giornalmente interagito dagli artisti. I TTozoi sistemano sulle loro tele alcune manciate d’acqua, farina e colore, un humus, dentro alla quale prolifera un microcosmo di muffe. Questi organismi crescono spandendosi a macchia di colore sul quadro fin quando trovano il cibo e incontrano la clemenza degli artisti, che ne arresteranno il processo più tardi, soffocandolo nel fissativo del tocco finale. L’intento di questo procedimento, è quello di cristallizzare l’azione della Natura; TTozoi sono spettatori attivi di una azione, che tenta di bloccare nel tempo un attimo di vita, che restituisce l’idea di una dimensione sospesa, che trattiene l’essere e racconta in qualche modo il divenire dell'opera attraverso un tempo controllato, quello “dell’informale fenomenologico e naturalmente assoluto”.
TTozoi (Stefano Forgione e Pino Rossi) vivono e lavorano ad Avellino.
I TTozoi esordiscono nel 2010 con la mostra personale “TTozoi – Muffe su tela” - Complesso Monumentale di Castel dell'Ovo a Napoli, a cura di Luca Beatrice. Nel 2012 sono a Berlino per “Schimmel auf Leinwand” (Muffe su tela), a cura di Carolina Lio, Walter I.A.V // alla Walter Bischoff Gallery. Partecipano alla 54ma BIENNALE DI VENEZIA (2012), Sala Nervi – Palazzo delle Esposizioni Torino e realizzano la personale Moulds on canvas a cura di Cynthia Penna e Alberto di Mauro, ART1307LLC presso l’Istituto Italiano di Cultura Los Angeles che li porta a “ART PLATFORM FAIR”, Santa Monica – LOS ANGELES (USA) dove vengono Inseriti tra i 10 artisti top della fiera (fonte: LAWEEKLY). Collaborano con: Galleria Raffaella Dechirico Torino; Galleria Zak Siena, Vecchiato Art Gallery Padova, Tedofra Art Gallery Bologna, Art 1307 Napoli, Art 13/07LLC Los Angeles.
La ricerca dei TTozoi muove dallo studio delle avanguardie storiche, dalle operazioni fenomenologiche dadaiste (dove la componente del caso gioca un ruolo determinante), dalle comparazioni kandinskyane dove “musica è colore, riverbero è azione, colore è capacità artistica ed espressione della natura, biomorfismo”. Esperienze queste che colpiscono l’immaginario dei TTozoi tanto quanto l’approccio operativo e il risultato informale delle opere, composte di gesto, segno e materia.
(R)EVOLUTION presenta una selezione di lavori inediti di TTozoi, ottenuti mediante un processo fisico-chimico naturale predisposto e giornalmente interagito dagli artisti. I TTozoi sistemano sulle loro tele alcune manciate d’acqua, farina e colore, un humus, dentro alla quale prolifera un microcosmo di muffe. Questi organismi crescono spandendosi a macchia di colore sul quadro fin quando trovano il cibo e incontrano la clemenza degli artisti, che ne arresteranno il processo più tardi, soffocandolo nel fissativo del tocco finale. L’intento di questo procedimento, è quello di cristallizzare l’azione della Natura; TTozoi sono spettatori attivi di una azione, che tenta di bloccare nel tempo un attimo di vita, che restituisce l’idea di una dimensione sospesa, che trattiene l’essere e racconta in qualche modo il divenire dell'opera attraverso un tempo controllato, quello “dell’informale fenomenologico e naturalmente assoluto”.
TTozoi (Stefano Forgione e Pino Rossi) vivono e lavorano ad Avellino.
I TTozoi esordiscono nel 2010 con la mostra personale “TTozoi – Muffe su tela” - Complesso Monumentale di Castel dell'Ovo a Napoli, a cura di Luca Beatrice. Nel 2012 sono a Berlino per “Schimmel auf Leinwand” (Muffe su tela), a cura di Carolina Lio, Walter I.A.V // alla Walter Bischoff Gallery. Partecipano alla 54ma BIENNALE DI VENEZIA (2012), Sala Nervi – Palazzo delle Esposizioni Torino e realizzano la personale Moulds on canvas a cura di Cynthia Penna e Alberto di Mauro, ART1307LLC presso l’Istituto Italiano di Cultura Los Angeles che li porta a “ART PLATFORM FAIR”, Santa Monica – LOS ANGELES (USA) dove vengono Inseriti tra i 10 artisti top della fiera (fonte: LAWEEKLY). Collaborano con: Galleria Raffaella Dechirico Torino; Galleria Zak Siena, Vecchiato Art Gallery Padova, Tedofra Art Gallery Bologna, Art 1307 Napoli, Art 13/07LLC Los Angeles.
26
giugno 2014
Ttozoi – (R)evolution
Dal 26 giugno al 10 luglio 2014
arte contemporanea
Location
GALLERIA ZAK
Monteriggioni, Piazza Roma, 13, (Siena)
Monteriggioni, Piazza Roma, 13, (Siena)
Orario di apertura
da martedì a domenica ore 11-13 e 17-22, lun su appuntamento
Vernissage
26 Giugno 2014, 19.00
Autore
Curatore